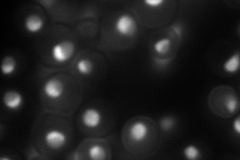
YDR083W
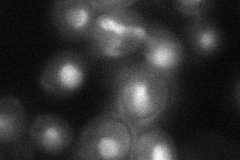
YDR083W

View description
Nucleolar protein involved in rRNA processing, pre-rRNA cleavage at site A2; also involved in telomere maintenance; mutation is synthetically lethal with a gar1 mutation
Localization:
Intensity:
Fold change:
Significance:
-
C’ GFP library in SD

below threshold15.03 -
N' NOP1pr-GFP in SD
nucleus,nucleolus147.009 -
N' TEF2pr-mCherry in SD

nucleus42.8929 -
N' NATIVEpr-GFP in SD

cytosol18.0535 -
N' TEF2pr-VC and Cyto-VN in SD
nucleus,nucleolus44.4659 -
C’ GFP library in SD+DTT

cytosol16.111.07No -
C’ GFP library in SD+H2O2

cytosol15.981.06No -
C’ GFP library in Starvation Media

cytosol16.451.09No -
C’ GFP library on the background of Pup2-DaMP

below threshold -
C’ GFP library on the background of CCT mutant

below threshold15.85431.054No
